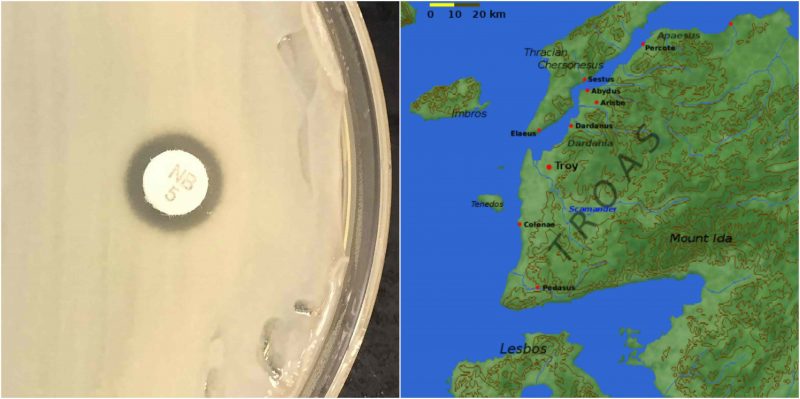

In modern-day Turkey, on the outer edges of the ancient city of Troy, the skeleton of a pregnant woman who died 800 years ago has produced the first record of death by an infection during pregnancy.
Researchers and historians have discovered an ancient skeleton of a woman who lived near the legendary city of Troy and the secrets of why she died. The Byzantine bones that researchers unearthed revealed both that she was pregnant and that a bacterial infection most likely was the cause of her death.

The 800-year-old bones, which had been entombed in a grave covered with stones, also revealed strawberry-sized lumps near her ribs.
After opening the bumps, the researchers found ‘ghost cells’ and were even able to remove and piece together completely the DNA of the infectious strain of bacteria that killed her. She was probably about 30 years old, and lived during the era of the Eastern Roman Empire.
Noted by the researchers in a statement, it was just amazing that the cells produced enough DNA to reconstruct the genetic material of two types of bacteria fully, Gardnerella vaginalis and Staphylococcus saprophyticus, which infected the woman and most likely led to her death.
The ancient DNA the scientists extracted and studied didn’t only come from the bacteria but also from the woman herself. In addition, they also studied the remains of what they believe was a male embryo. The statement went on to say, in layman’s terms, that the calcification accumulation made little tiny suitcases of DNA and carried it across an 800-year timespan.
Interestingly, the researchers think that one of the primitive strains of bacteria, Staphylococcus saprophyticus, populated a different niche during this time and jumped between livestock and humans at a time when it was customary for individuals to cohabitate with animals.

The bacterial strain from the ancient city of Troy belongs to a lineage that is not typically related to human disease in today’s modern world. The researchers further speculated that human infections and diseases in the ancient world, as in the Byzantine Empire, were acquired from a collective of bacteria that moved uninhibited between the environment, people, and livestock.
Read another story from us: Landnám, loot, and long-distance trade: understanding Viking economics
The researchers believe that the woman had a difficult rural farming life and that the bacterial infection that slew her was connected to her pregnancy. Their investigation, research, and studies of the ancient bones have been published in the journal eLIFE.